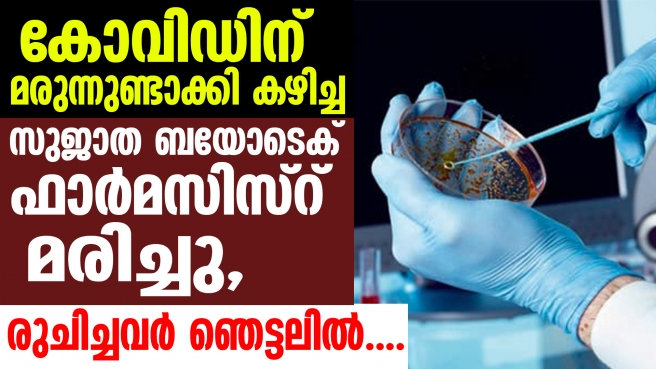

കോവിഡിന് മരുന്നുണ്ടാക്കി സ്വയം പരീക്ഷിച്ച ഫാര്മസിസ്റ്റ് മരിച്ചു; ചെന്നൈ കേന്ദ്രമാക്കി പ്രവര്ത്തിക്കുന്ന സുജാത ബയോടെക് ഫാര്മസിസ്റ് ശിവനേശനാണ് മരിച്ചത്; മരുന്ന് രുചിച്ച് നോക്കിയ കമ്പനി എം.ഡി. ഡോ. രാജ്കുമാര് ബോധരഹിതനായി, ഒടുവില്....
കോവിഡ് -19 എന്ന മഹാമാരി ലോകം മുഴുവന് നാശം വിതയ്ക്കുകയാണ്.ലക്ഷക്കണക്കിന് ആളുകളാണ് കൊറോണ എന്ന ഈ മാരക വൈറസിന്റെ അക്രമത്തില് ഇപ്പോള് കൊല്ലപ്പെട്ടത്. അതുകൊണ്ടുതന്നെ ഈ മഹാമാരിക്ക് പ്രതിരോധ വാക്സിനോ മരുന്നോ കണ്ടെത്താനുള്ള പരിശ്രമത്തിലാണ് വിവിധ രാജ്യങ്ങള്.
എന്നാല് ചിലര് ആരോഗ്യ വകുപ്പിന്റെയോ ഗവണ്മെന്റിന്റെയോ മുന്നറിയിപ്പുകള് ഒന്നും തന്നെ വക വെക്കാതെ സ്വയ ചികിത്സ നടത്തുന്നുണ്ട്.അത് വലിയ അപകടമാണ് ക്ഷണിച്ചു വരുത്തുന്നതും. ഇപ്പോഴിതാ മറ്റൊരു ഞെട്ടിപ്പിക്കുന്ന വാര്ത്ത പുറത്തു വരുന്നു. കോവിഡ്-19 ചികിത്സയ്ക്കുള്ള മരുന്നുണ്ടാക്കി സ്വയം പരീക്ഷിച്ച ഫാര്മസിസ്റ്റ് മരിച്ചു എന്നതാണ് ആ വാര്ത്ത.. ആയുര്വേദ മരുന്നുകള് ഉത്പാദിപ്പിക്കുന്ന സുജാത ബയോടെക് കമ്പനിയിലെ പ്രൊഡക്ഷന് മാനേജരായിരുന്ന ശിവനേശനാണ് (47) മരിച്ചത്. ഇയാള് തയ്യാറാക്കിയ മരുന്ന് രുചിച്ച് നോക്കിയ കമ്പനി എം.ഡി. ഡോ. രാജ്കുമാര് ബോധരഹിതനായെങ്കിലും ആശുപത്രിയിലെ ചികിത്സയെത്തുടര്ന്ന് രക്ഷപ്പെട്ടു.
ചെന്നൈ കേന്ദ്രമായി പ്രവര്ത്തിക്കുന്ന കമ്പനിയുടെ ഉത്തരാഖണ്ഡിലുള്ള നിര്മാണ യൂണിറ്റിലായിരുന്നു ശിവനേശന് ജോലി ചെയ്തിരുന്നത്. ചെന്നൈ പെരുങ്കുടിയില് കുടുബാംഗങ്ങളെ കാണാന് എത്തിയ ഇയാള്ക്ക് ലോക്ക് ഡൗണിനെ തുടര്ന്ന് തിരികെ പോകാന് സാധിച്ചില്ല. ഇതിനിടെയാണ് ഇയാള് ചില രാസവസ്തുകള് ചേര്ത്ത് കോവിഡിന് മരുന്ന് കണ്ടെത്താനുള്ള പരീക്ഷണം നടത്തിയത്. ചെന്നൈ പാരീസ് കോര്ണറില്നിന്നാണ് മരുന്നിനുള്ള അസംസ്കൃത വസ്തുകള് ഇദ്ദേഹം വാങ്ങിയത്.
പൊടിരൂപത്തിലുള്ള മരുന്ന് ആദ്യം ഡോ. രാജ്കുമാറിന് രുചിക്കാന് നല്കിയ ശിവനേശന് പിന്നീട് ഇതുവെള്ളത്തില് കലക്കി കുടിക്കുകയായിരുന്നു. ബോധരഹിതരയായ ഡോ. രാജ്കുമാറിനെയും ശിവനേശനെയും ഉടന് ആശുപത്രിയില് എത്തിച്ചുവെങ്കിലും ശിവനേശന്റെ ജീവന് രക്ഷിക്കാനായില്ല. ആശുപത്രിയില് എത്തുന്നതിന് മുമ്പുതന്നെ ഇയാള് മരിച്ചു. സംഭവത്തില് തേനാംപേട്ട് പോലീസ് കേസെടുത്തിട്ടുണ്ട്. അസ്വാഭാവിക മരണത്തിനാണ് കേസ്. എന്നാല് ശിവനേശന് സ്വന്തം നിലയിലാണ് മരുന്നുണ്ടാക്കിയതെന്നും തങ്ങള് ആയുര്വേദ ചികിത്സാവിധി പ്രകാരമുള്ള മരുന്നുകള് മാത്രമാണ് ഉത്പാദിപ്പിക്കുന്നതെന്നും കമ്പനി വിശദീകരിച്ചു.
https://www.facebook.com/Malayalivartha























